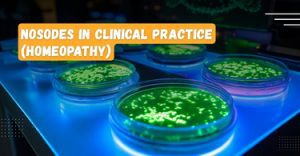

-
Dr Shubham Bhadekar
MD scholar , Department of Homeopathic Materia Medica, District Homeopathic Medical College and hospital Ratlam (Madhya Pradesh)
Posts
Nosodes in Clinical Practice (Homeopathy)
Nosodes in Clinical Practice (Homeopathy) Abstract:-Nosodes play an important role in the management of chronic diseases by acting on the underlying miasmatic background, thereby improving...

